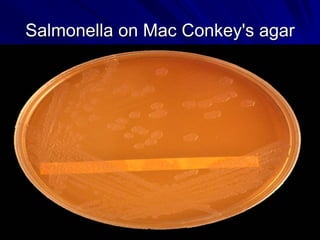
Salmonella on Mac Conkey's agar

Embed presentation
Downloaded 10,785 times




































































Typhoid fever is caused by the bacterium Salmonella typhi. It remains a major public health problem, infecting over 21 million people annually and causing over 200,000 deaths per year globally. The disease is transmitted through contaminated food or water. Clinical features include a sustained high fever over several weeks and complications can include intestinal bleeding or perforation. Diagnosis is made through blood or stool cultures. Treatment involves antibiotics. Prevention relies on vaccination, improved sanitation and hygiene practices like handwashing to control the spread from infected cases and carriers.